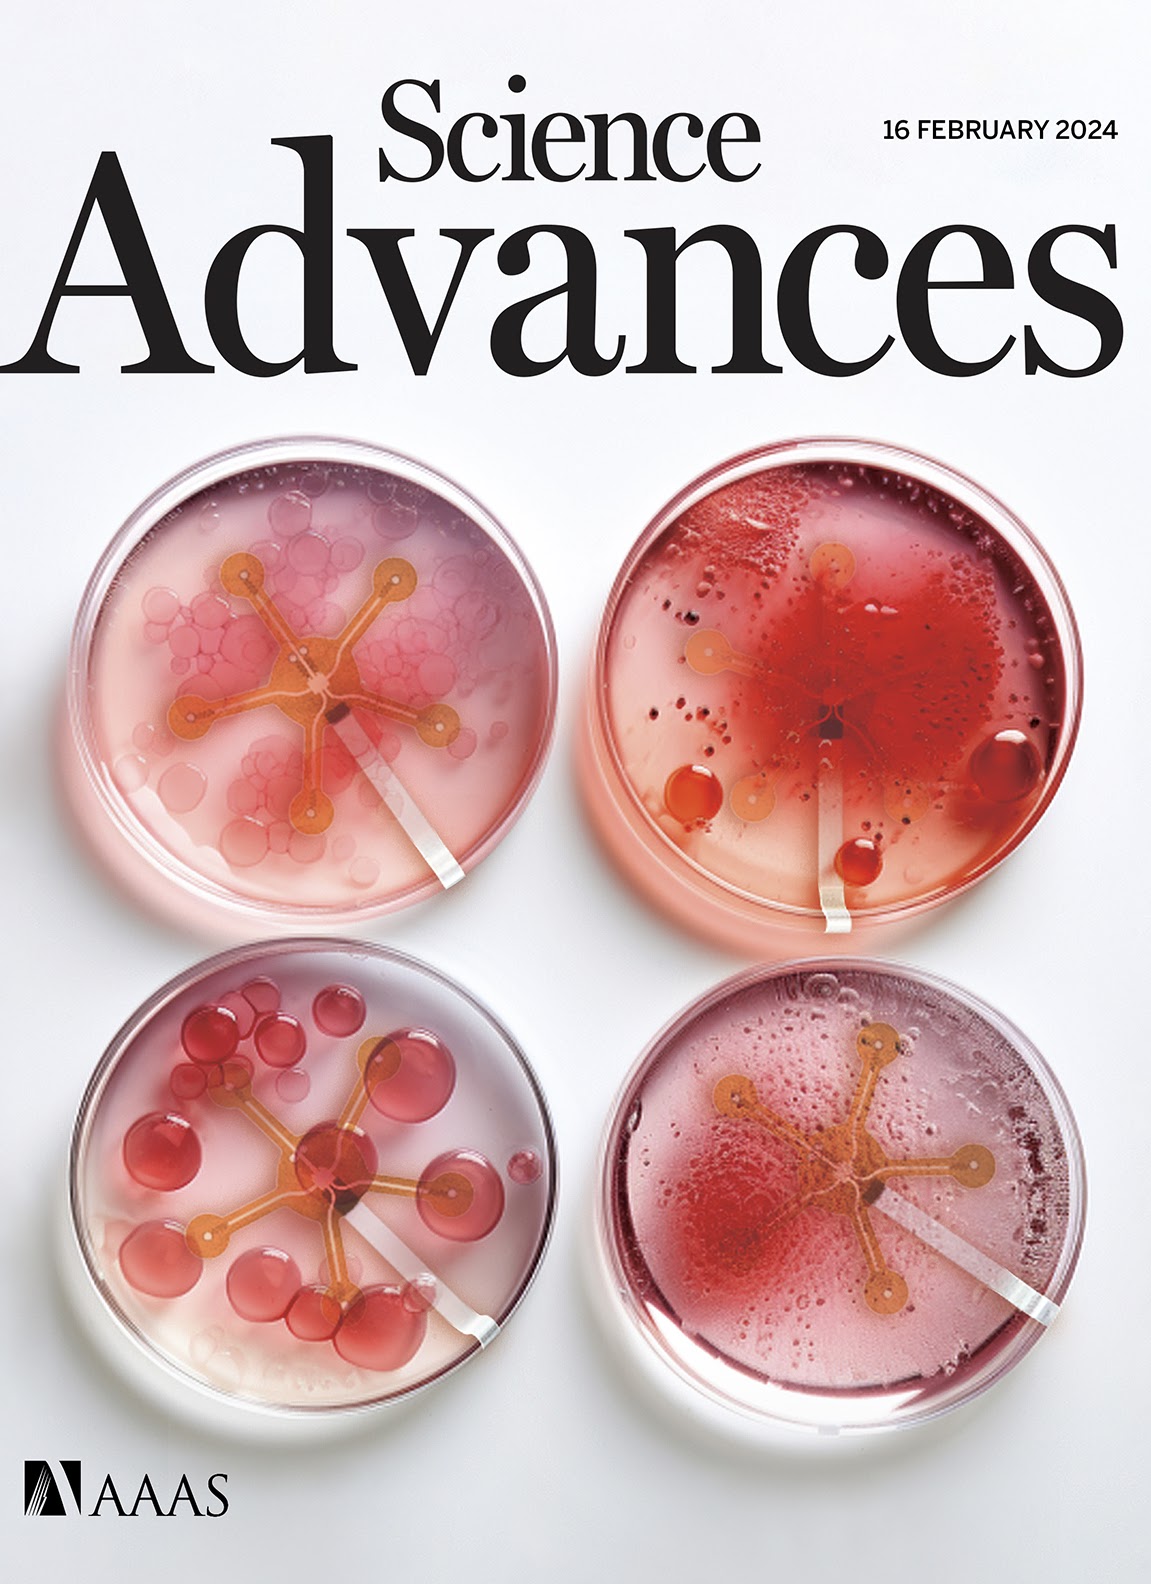

Smart Bioreactor System Overcomes Limitations in Cell Manufacturing
By Jerry Grillo
Personalized medicine using stem cells has the potential to push the clinical limits, leading to powerful therapeutic options for patients battling previously untreatable diseases. Stem cell therapies already are being used to battle some cancers, such as leukemia and lymphoma.
However, the integration of stem cell therapies into the medical mainstream faces a significant hurdle: absence of a reliable manufacturing platform that can ensure the large-scale, consistent production of clinical-grade stem cells, while maintaining optimal quality.
“That’s very important and it presents a huge challenge to expanding the use of these revolutionary, often life-saving cell therapies,” said Georgia Tech researcher W. Hong Yeo, Woodruff Faculty Fellow and associate professor in both the Woodruff School of Mechanical Engineering and the Wallace H. Coulter Department of Biomedical Engineering at Georgia Tech and Emory University.
Yeo addresses the challenge in a new multi-institutional study describing a smart bioreactor system, published this week and featured as the journal cover article in Science Advances. Bioreactors are an essential part of stem cell manufacturing. They provide a stable environment for stem cell cultivation within a chemical soup, where the cells multiply.
“In that cell culture are four important parameters that we need to monitor – pH, dissolved oxygen, temperature, and glucose. Real-time, continuous monitoring of these values is directly related to the final quality of the cells that you’re creating,” said Yeo. “Currently, most people measure those parameters before and after.”
Even state-of-the-art bioreactors are restricted in what they can measure due to limited sensor performance.
“So, in many cases, we have no idea what’s happening during the culture process, which can take days, more than a week,” Yeo said. “It’s a long time to wait, and sometimes we get good, quality cells. And sometimes, we can lose an entire batch. Thus, we need better sensors.”
Yeo’s lab specializes in developing multiple technologies, often involving wearable, soft or implantable electronics and biosensors, for health monitoring and disease diagnostics. For this study they developed a smart bioreactor system that integrates ultrathin membrane sensors with multifunctionality, to make measurements in real time at a large scale.
Their system can provide wireless culture monitoring and provide real time feedback for up to 30 days, “which means manufacturers can make adjustments immediately, based on the data they are gathering,” said Yeo, director of the Wearable Intelligent Systems and Healthcare (WISH) Center in the Institute for Electronics and Nanotechnology (IEN). “The idea is to provide continuous, long-term monitoring of those parameters, to ensure quality cell products.”
The Yeo lab's research received the cover treatment.
Yeo collaborated with Young Jang, associate professor in Coulter Department, the Emory School of Medicine, and Georgia Tech’s School of Biology. His lab provided the stem cells that Yeo’s bioreactor system tested. In addition to Georgia Tech and Emory, the team included researchers from the Atlanta VA Medical Center, the San Diego Institute of Science, the Biomedical Engineering and Imaging Institute (Mt. Sinai, NY), and Pukyong National University (Republic of Korea). The researchers gave the bioreactor system a thorough test-run, demonstrating its efficacy on five different cell types.
“We wanted to demonstrate the versatility and scalability of this system,” said Yeo. “Because if you think about the end users, the patients, and you think about getting these new therapies to the people who need them, you can’t just think just in terms of small batches of cells. You must think bigger.”
CITATION: Jimin Lee, Hojoong Kim, Hyo-Ryoung Lim, Yun Soung Kim, Thi Thai Thanh Hoang, Jeongmoon Choi, Gun-Jae Jeong, Hodam Kim, Robert Herbert, Ira Soltis, Ka Ram Kim, Sung Hoon Lee, Youngjin Kwon, Yunki Lee, Young Charles Jang, and Woon-Hong Yeo. “Large-scale smart bioreactor with fully integrated wireless multivariate sensors and electronics for long-term in situ monitoring of stem cell culture,” Science Advances (February 14, 2024). DOI: 10.1126/sciadv.adk67
FUNDING: This research was supported by the Marcus Foundation, the Georgia Research Alliance, and the Georgia Tech Foundation through their support of the Marcus Center for Therapeutic Cell Characterization and Manufacturing (MC3M) at Georgia Tech. Also, this work was partially funded by the IEN Center for Human-Centric Interfaces and Engineering at Georgia Tech and the NSF Engineering Research Center for Cell Manufacturing Technologies (CMaT).
COMPETING INTERESTS: Yeo is an inventor on a pending patent application related to this work.